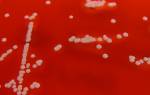

Что такое золотистый стафилококк
Золотистый стафилококк (Staphylococcus aureus) — это круглая бактерия золотистого оттенка, относящаяся к роду стафилококков. Впервые этот микроорганизм был обнаружен Александром Огстоном в 1880 году в гнойных абсцессах, а через 4 года Отттомаром Розенбахом было дано его описание.
Удивительной устойчивостью обладает данный микроорганизм. Он способен выдерживать высокие температуры, воздействие солнечных лучей, спирта, перекиси водорода и многих видов антибиотиков.
Данные мировой организации здравоохранения свидетельствуют о том, что распространение стафилококковой инфекции наиболее распространено среди медицинских учреждений. Заражение этой инфекцией является основной причиной смерти в больницах.
Причины возникновения
Поскольку многие люди являются носителями этого микроорганизма, полностью избежать заражения невозможно. За многие годы бактерия претерпела значительные изменения и приобрела способность выживать в различных условиях. Её устойчивость к антибиотикам значительно возросла, и избавиться от неё быстро и надолго — непростая задача.
Получить золотистый стафилококк можно несколькими способами:
- Способ передачи через контакт (при касании и использовании зараженных предметов)
- Передача через воздушно-капельный механизм (при чихании, кашле, дыхании)
- Передача через пыль (при вдыхании загрязненной пылью)
- Передача через орально-фекальный механизм (при рвоте, дефекации, употреблении зараженной пищи)
- Через использование медицинских инструментов (в реанимации, стоматологии, гинекологии, оториноларингологии, при гемодиализе)
В медицинской практике известно более 100 заболеваний, вызванных стафилококковой инфекцией.
Симптомы
Когда стафилококк попадает в организм, он начинает производить токсины и ферменты. Эксфолиатин, энтеротоксин и лейкоцидин вызывают отравление организма, нарушая функционирование внутренних органов. Симптомы заражения значительно разнятся в зависимости от того, где находится инфекция.
- Если кожа поражена, то могут появиться воспалительные высыпания, такие как прыщи, фурункулы и абсцессы.
- Поражение ЛОР-органов может привести к развитию отита, бронхита и других острых респираторных заболеваний.
- Поражение лёгких может вызвать развитие пневмонии, абсцессов и плеврита.
- Если поражен головной мозг, то это может привести к развитию менингита и тромбофлебита.
Все эти условия имеют свои уникальные особенности и требуют персонализированного подхода к выбору методов лечения.
Иммунная система человека играет значительную роль в проявлении симптомов. Она представляет собой мощный фактор, способный подавлять развитие заболеваний.
Диагностика
Определение заболевания включает в себя проведение лабораторного анализа. Для проведения анализа используются жидкости организма (кровь, моча, слюна, мазок). После этого проводится бактериологическое исследование биоматериала с определением чувствительности к антибиотикам. Проведение этого исследования занимает не менее трех дней.
Присутствие бактерий в теле не обязательно означает возникновение инфекции, вызванной стафилококками. Даже при умеренном уровне их размножения, заболевание может не проявиться. Установление диагноза основывается на сочетании уровня размножения бактерий и клинических проявлений.
Лечение
Лечение инфекции, вызванной стафилококками, представляет собой непростую задачу. Ассортимент лекарств, предназначенных для борьбы с этим заболеванием, можно разделить на несколько категорий:
- Препараты, усиливающие иммунитет.
- Средства, стимулирующие биологические процессы.
- Препараты на основе бактериофагов.
- Профилактические препараты.
- Сыворотки для профилактики и лечения.
- Препараты для борьбы с инфекциями.
- Антисептики на растительной основе.
Препараты для модуляции иммунной системы и биологические стимуляторы помогают организму поддерживать ситуацию под контролем. Если человек является всего лишь переносчиком бактерии, даже в высоких концентрациях, хороший иммунитет предотвратит развитие инфекции. А в случае заболевания и активного лечения различными препаратами, укрепление иммунитета поможет перенести болезнь быстрее и легче.
Фаги, нападающие на бактерии, обладают сильным бактерицидным действием. Проникая внутрь бактериальной клетки, они размножаются за счёт её ресурсов. Это приводит к гибели бактерии, а увеличившееся количество фагов переходит на следующую клетку. Например, стафилококковый бактериофаг не способен воздействовать на другие виды бактерий. При этом он абсолютно безвреден для организма человека.
Прививки способствуют созданию стойкого иммунитета к возбудителю инфекции.
Сыворотка иммуноглобулиновая производится из крови доноров и имеет мощное антибактериальное действие.
Иммуноглобулин против стафилококков содержит антитела, направленные против токсинов стафилококка.
Препараты антибиотического действия — это лекарства, которые способны уничтожать бактерии. Их применение рекомендуется только после определения чувствительности возбудителя к ним. Неправильное использование таких препаратов приводит к увеличению устойчивости микроорганизмов. Среди наиболее часто применяемых видов антибиотиков можно выделить следующие:
- Амоксициллин.
- Ванкомицин.
- Цефазолин.
- Оксациллин.
- Цефалексин.
- Цефалотин.
- Цефотоксин.
- Эритромицин.
- Клиндамицин.
Продукты на основе хлорофиллипта, полученного из растений, являются наиболее эффективными антисептиками. Их спиртовые и масляные формы применяются для обработки кожи и увлажнения слизистых оболочек.
Осложнения
Если лечение бактериальных инфекций не начато своевременно, это может привести к возникновению серьезных осложнений, угрожающих жизни.
Самым распространенным осложнением является развитие воспаления внутренней оболочки сердца. Происходит поражение мышечных слоев сердца и клапанов. Пациент испытывает боли в суставах, учащенное сердцебиение, повышенную температуру, быструю утомляемость.
Эндокардит
Вторым по частоте заболеванием является менингит (воспаление оболочек вокруг мозга). Прогрессирует быстро, даже если начать антибактериальное лечение вовремя. Человек ощущает сильные головные боли, судороги, увеличивается температура тела, возникает тошнота и рвота. Даже при правильной терапии смертность от менингита составляет примерно 30%.
Сепсис (инфекция крови), очень опасное осложнение с высоким уровнем смертности. Развивается из-за проникновения токсинов стафилококка в кровь. Это заболевание воздействует на все органы. Без проведения бактериологического анализа с определением чувствительности к антибиотикам терапия может оказаться неэффективной.
Токсический шок возникает в ответ на воздействие инфекционного агента на организм. У пациента происходит резкое повышение температуры тела (до 40°), возникают рвота и понос, снижается артериальное давление. Это состояние характеризуется высокой смертностью.
Профилактика
Важно знать, что предупреждение заражения стафилококком включает несколько ключевых моментов.
Необходимо:
- Соблюдать правила личной гигиены и санитарии.
- Проводить дезинфекцию очагов инфекции (глаз, нос, горло, зубы).
- В период заболеваний, делать прививки.
- Избегать запущенных кожных заболеваний, обрабатывать раны и порезы.
- Поддерживать чистоту в доме и в гардеробе.
- Избегать употребления просроченной пищи.
- Избегать посещения недостоверных салонов красоты, тату-салонов и соляриев.
- Укреплять иммунитет с помощью здорового образа жизни и правильного питания.
Следование этим инструкциям поможет уменьшить вероятность заражения этим вредным микроорганизмом.
Частые вопросы
Как передается золотистый стафилококк?
Золотистый стафилококк передается через контакт с инфицированными поверхностями или через контакт с инфицированными людьми или животными.
Какие симптомы вызывает золотистый стафилококк?
Симптомы инфекции золотистым стафилококком могут включать в себя покраснение, опухание, боль, гнойничковые высыпания и повышение температуры тела.
Каковы методы лечения и профилактики золотистого стафилококка?
Лечение золотистого стафилококка может включать в себя прием антибиотиков, дренирование гнойничковых образований и местное лечение. Профилактика включает в себя соблюдение правил гигиены, регулярное мытье рук, чистку ран и уход за кожей.
Полезные советы
СОВЕТ №1
Признаки золотистого стафилококка включают в себя покраснение, опухание и болезненность кожи, а также наличие гнойничков. Если у вас появились подобные симптомы, обратитесь к врачу для диагностики.
СОВЕТ №2
Лечение золотистого стафилококка обычно включает прием антибиотиков под наблюдением врача. Важно следовать рекомендациям врача и завершить полный курс лечения, чтобы предотвратить рецидивы и развитие устойчивости к антибиотикам.
СОВЕТ №3
Для профилактики золотистого стафилококка рекомендуется соблюдать правила гигиены, регулярно мывать руки, избегать контакта с открытыми ранами и уязвимыми местами на коже, а также использовать антисептические средства при необходимости.